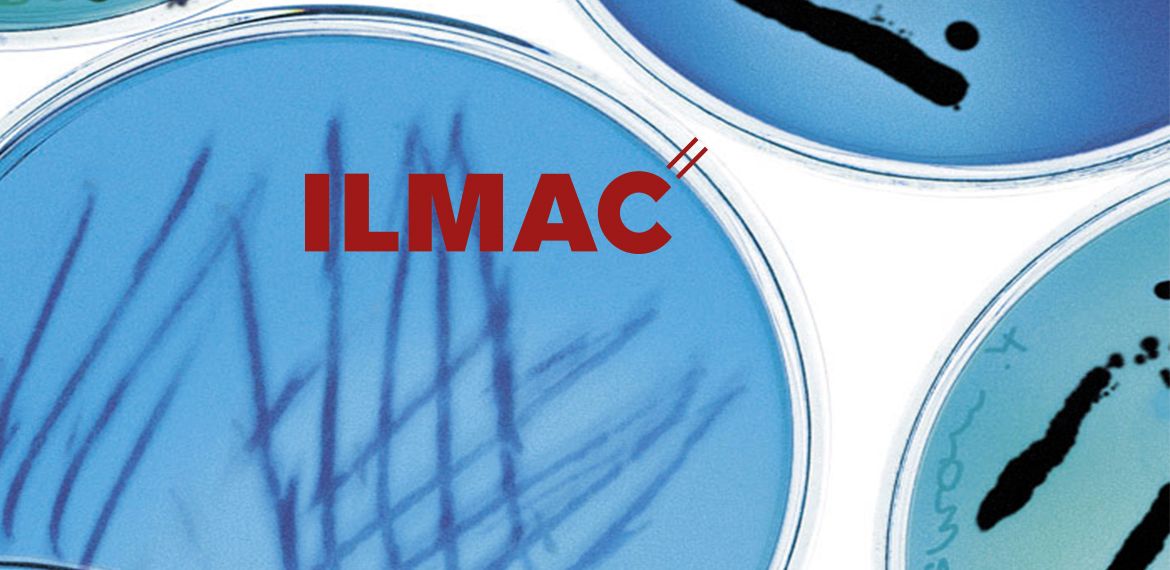
ILMAC 2019

ILMAC 2019
vom 24.-27. September in Basel, Halle 1 Stand C161
Zum 60. Mal öffnet die ILMAC in Basel, wichtigste Schweizer Fachmesse für Prozess- und Labortechnik, am 24. September 2019 ihre Tore. Die HUBERLAB. AG ist seit 1968 mit einem eigenen Stand für ihre Kunden vor Ort.
2019 erwartet die Messebesucher bei HUBERLAB. mehr als Altbekanntes.
HUBERLAB. IS MORE – der Besuch am HUBERLAB. Stand stellt den Menschen, seine Werte, Leistungen und Expertise in den Mittelpunkt. 360° mehr Flexibilität, mehr Services und mehr Gastlichkeit nachhaltig und kompetent.
Präsentiert: Digitale Power, nachhaltige einzigartige Services & Laborneuheiten.
Offeriert: Cocktails, regionale Spezialitäten, Fotowettbewerb & Networking.
Real People. Real Expertise. - 360° - 24/7 – committed to science – committed to you!
Melden Sie sich zu unserem Webinar an
«anvajo presents: fluidlab R-300»
Lernen Sie das kleinste, portable Laborgerät kennen, dass Zellzählung und Spektrometrie kombiniert.
25-jähriges Jubiläum
Seit einem Vierteljahrhundert wirbelt der umtriebige Nicola Mele nun schon durch die HUBERLAB. Welt.
Wir sagen DANKE!
Mit «More Digital Power» ins neue Jahr
Es ist wieder soweit: Jahresbeginn und somit Zeit für neue Vorsätze.